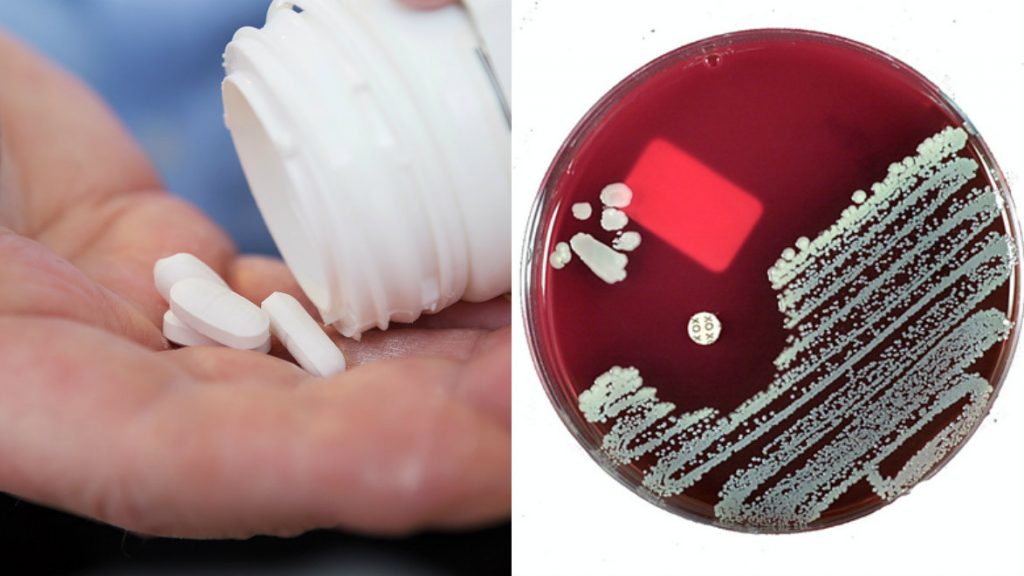
Användningen av antibiotika behöver minska ännu mer för att motverka resistenta bakterier.

Yoga leder till minskad paranoia och ångest bland intagna på fängelseanstalter. Det visar resultatet av en ny västsvensk studie som fått internationell uppmärksamhet. Två personer…
Inlägg publicerade i “Vård”
Västra Götalandsregionen (VGR) kan nu erbjuda en ny digital hörapparat som kan förändra livet för många med nedsatt hörsel. En av dem som lovprisar den…
Antalet recept på antibiotika minskar i Västra Götalandsregionen (VGR). – Vi ligger bra till jämfört med övriga Sverige och framförallt jämfört med andra länder. Men…
Léah Martinsson har levt med panikångest i hela sitt liv. Misshandel, mobbning och sexuella övergrepp, gjorde henne sjuk i posttraumatiskt stressyndrom. En KBT-behandling på Södra…
Barn och unga som har varit med om så svåra händelser att de drabbats av posttraumatiskt stressyndrom kan få hjälp på en specialistmottagning på Södra Älvsborgs…
Redan fyra veckors nykterhet före en operation kan leda till halverad risk för komplikationer. Nu tittar Västra Götalandsregionen (VGR) på att införa regiongemensamma riktlinjer för…
Sexlivet kan påverkas och förändras efter en sjukdom eller behandling. Därför har Skaraborgs Sjukhus (SkaS) en specialist i sexologi som ska få vårdpersonal att våga…
Mentor, livsstilscoach eller certifierad medmänniska? Naseer Tariq är Peer supporter på psykosavdelningen på Kungälvs sjukhus. Rollen är helt ny inom sjukvården och är ett pilotprojekt…
Idag öppnar NU-sjukvården Västra Götalandsregionens (VGR) första sprututbytesmottagning. – Vi öppnar dörren för människor som sjukvården annars har svårt att nå. Här får de inte…
Skulle du klara att springa ett motionslopp om dagen i en vecka utan att kollapsa? Då klarar du förmodligen också att drabbas av influensa. Men…